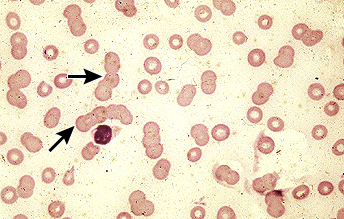

[RES18]
0
여기에 표시한 문제들은 마이노트에서 모아볼 수 있어요!
72세 남성이 지속적인 체중 감소와 약 3주 전부터 느껴진 전반적인 무기력함을 호소하며 병원을 찾았다. 실시한 혈액검사와 말초혈액 도말검사 결과는 다음과 같다. 이 환자에게 추가로 필요한 검사는 무엇인가?
WBC 6,200/mm3, Hb 6.8 g/dL, PLT 190,000/mm3
Protein/Albumin 11.2/3.3 g/dL,
AST/ALT 20/19 U/L
BUN/Cr 22/1.9 mg/dL
정답률 94%
누적 풀이 횟수 1,500+
평균 풀이 시간28초
/
나의 풀이 시간0초
Imp: Multiple myeloma
해설
AG ratio reverse가 있으면서, anemia가 있고, Cr이 높아 renal dysfunction이 확인되며, PBS 상에서 Rouleaux formation이 있다. Multiple myeloma가 의심되기 때문에, 혈청과 소변 단백 전기영동 검사가 필요하다.
오답 선지
• 뇌 자기공명영상 : 다발골수종에서 시행할 수 있으나 현재는 진단을 위해 단백전기영동검사가 우선이다.
• PET : 다발골수종에서 시행할 수 있으나 현재는 진단을 위해 단백전기영동검사가 우선이다.
• 심초음파 : 다발골수종의 CRAB과 연관성이 떨어진다.
• 뼈스캔: 최근 뼈스캔이 다발골수종에서는 도움이 되지 않는다는 문제가 임종평을 비롯해서 나온다. 쉽게 풀 수 있는 문제였으나 도움이 되지 않는다는 것도 챙기면 좋다.
Tip :
다발골수종은 CRAB 증상이 있는 경우에 치료한다는 것도 알아두자.
관련 이론
• 다발골수종 및 기타 혈액암
• AG reverse (알부민 대 글로불린(A/G) 비율 역전)
이 비율은 혈액 내 알부민 대 글로불린 수준을 비교한다. 정상적인 A/G 비율은 1보다 크며 이는 글로불린보다 알부민이 더 많다는 것을 나타낸다. 그러나 다발성 골수종에서는 주로 글로불린 범주에 속하는 단클론 단백질(Monoclonal antibody)의 과잉 생산으로 인해 이 비율이 1미만으로 역전될 수 있다.
A/G 비율 역전이 중요한 지표이기는 하지만, 다발성 골수종을 진단할 수 있는 것은 아니다. 진단에는 단백질 전기영동검사, 골수검사 등이 필요하다.
• gammopathy의 진단기준 : monoclonal gammopathy가 꼭 multiple myeloma라는 것이 아니라는 것만 이해하고 넘어가자!
Condition | Criteria | Details |
|---|---|---|
Definition of multiple myeloma | Clonal bone marrow plasma cells ≥10% or biopsy-proven bony or extramedullary plasmacytoma and any one or more of the following myeloma-defining events: | Evidence of end-organ damage that can be attributed to the underlying plasma cell proliferative disorder, specifically: > Hypercalcemia: serum calcium >0.25 mmol/L (>1 mg/dL) higher than the upper limit of normal or >2.75 mmol/L (>11 mg/dL), > Renal insufficiency: creatinine clearance <40 mL per min or serum creatinine >177 μmol/L (>2 mg/dL), > Anemia: hemoglobin value of >20 g/L below the lower limit of normal, or a hemoglobin value <10 g/dL, > Bone lesions: one or more osteolytic lesions on skeletal radiography, CT, or PET-CT |
Clonal bone marrow plasma cell percentage ≥60%, Involved:uninvolved serum free light chain ratio >100, >1 focal lesions on MRI studies | ||
Definition of smoldering multiple myeloma | Both criteria must be met: | Serum monoclonal protein (IgG or IgA) ≥30 g/L or urinary monoclonal protein ≥500 mg per 24 hours and/or clonal bone marrow plasma cells 10 to 59%, Absence of myeloma defining events or amyloidosis |
Definition of monoclonal gammopathy of undetermined significance (MGUS) | All three criteria must be met: | Serum monoclonal protein <30 g/L, Bone marrow plasma cells <10%, Absence of myeloma defining events or amyloidosis (or Waldenström macroglobulinemia in the case of IgM MGUS) |
다발골수종은 1) 형질세포의 증식 + 2) 그로 인한 조직의 파괴(CRAB)로 정의되는 것이다.
Reference
• Harrison 21e, pp.802-809, 866-878
• 이미지: Lytic lesion, SPEP, immunofixation, 지문의 rouleax formation